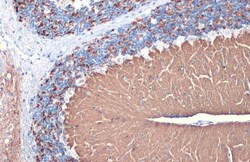
Invitrogen VGLUT1 Polyclonal Antibody 100 &mu;L; Unconjugated:Anticuerpos

Learn More
Invitrogen™ VGLUT1 Polyclonal Antibody


Rabbit Polyclonal Antibody
Marca: Invitrogen™ PA585764
Descripción
Keep as concentrated solution. Predicted reactivity: Human (96%), Mouse (100%), Rat (98%), Bovine (100%). Positive Control: mouse brain, rat brain. Store product as a concentrated solution. Centrifuge briefly prior to opening the vial.
A Na(+)-dependent inorganic phosphate cotransporter; may be involved in neuronal Na+ transport.
Especificaciones
| VGLUT1 | |
| Polyclonal | |
| Unconjugated | |
| SLC17A7 | |
| 2900052E22Rik; AI851913; BNPI; Brain-specific Na(+)-dependent inorganic phosphate cotransporter; brain-specific Na-dependent inorganic phosphate cotransporter; SLC17A1; SLC17A1/VGLUT1; Slc17a7; solute carrier family 17 (sodium-dependent inorganic phosphate cotransporter), member 7; solute carrier family 17 (vesicular glutamate transporter), member 7; solute carrier family 17 member 7; Vesicular glutamate transporter 1; VGlU1; VGLUT 1; VGLUT1 | |
| Rabbit | |
| Antigen affinity chromatography | |
| RUO | |
| 116638, 72961 | |
| Store at 4°C short term. For long term storage, store at -20°C, avoiding freeze/thaw cycles. | |
| Liquid |
| Immunohistochemistry (Frozen), Immunohistochemistry (Paraffin), Western Blot, Immunocytochemistry | |
| 1.85 mg/mL | |
| PBS with 20% glycerol and 0.025% ProClin 300; pH 7 | |
| Q3TXX4, Q62634 | |
| SLC17A7 | |
| Recombinant protein encompassing a sequence within the Intracellular domain of mouse VGluT1. The exact sequence is proprietary. | |
| 100 μL | |
| Primary | |
| Mouse, Rat | |
| Antibody | |
| IgG |
Al hacer clic en Enviar, acepta que Fisher Scientific se ponga en contacto con usted en relación con los comentarios que ha proporcionado en este formulario. No compartiremos su información para ningún otro fin. Toda la información de contacto proporcionada se mantendrá de acuerdo con nuestra Política de Privacidad. Política de privacidad.